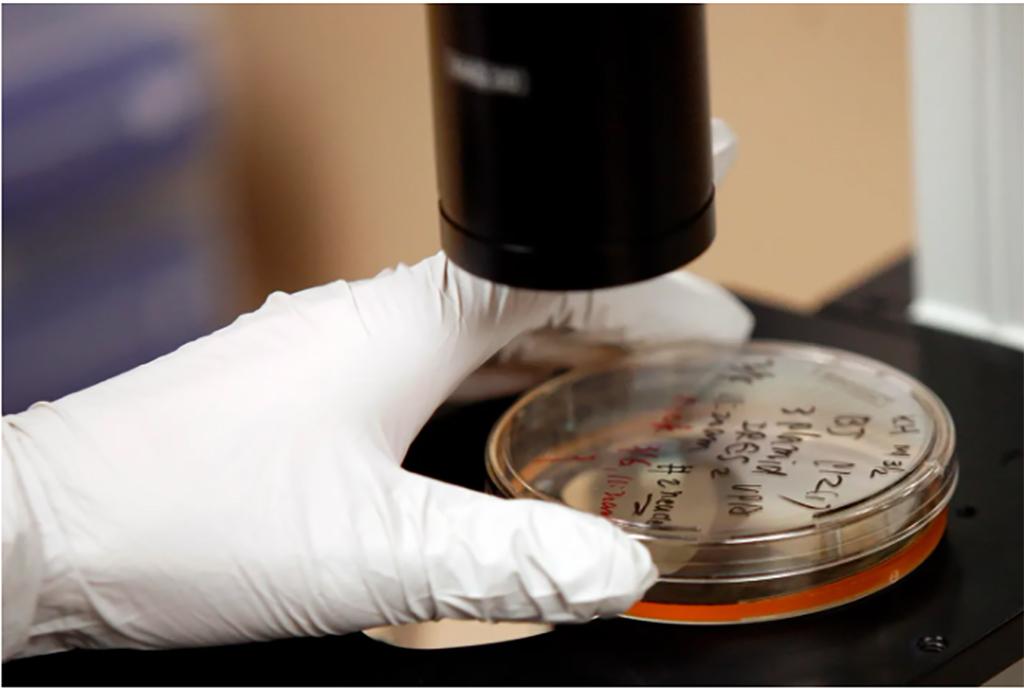
Thêm hy vọng về khả năng chữa khỏi bệnh HIV/AIDS

Ngành Y tế Ninh Bình: Đẩy mạnh thi đua, nâng cao chất lượng khám, chữa bệnh chào mừng Đại hội Đảng toàn quốc lần thứ XIV
Trong không khí cả nước hướng về Đại hội Đảng toàn quốc lần thứ XIV, ngành Y tế tỉnh Ninh Bình đã đẩy mạnh triển khai nhiều phong trào thi đua, hoạt động thiết thực, nâng cao chất lượng dịch vụ khám chữa bệnh, đảm bảo sức khoẻ nhân dân, lập tích tích chào mừng sự kiện chính trị đặc biệt này.